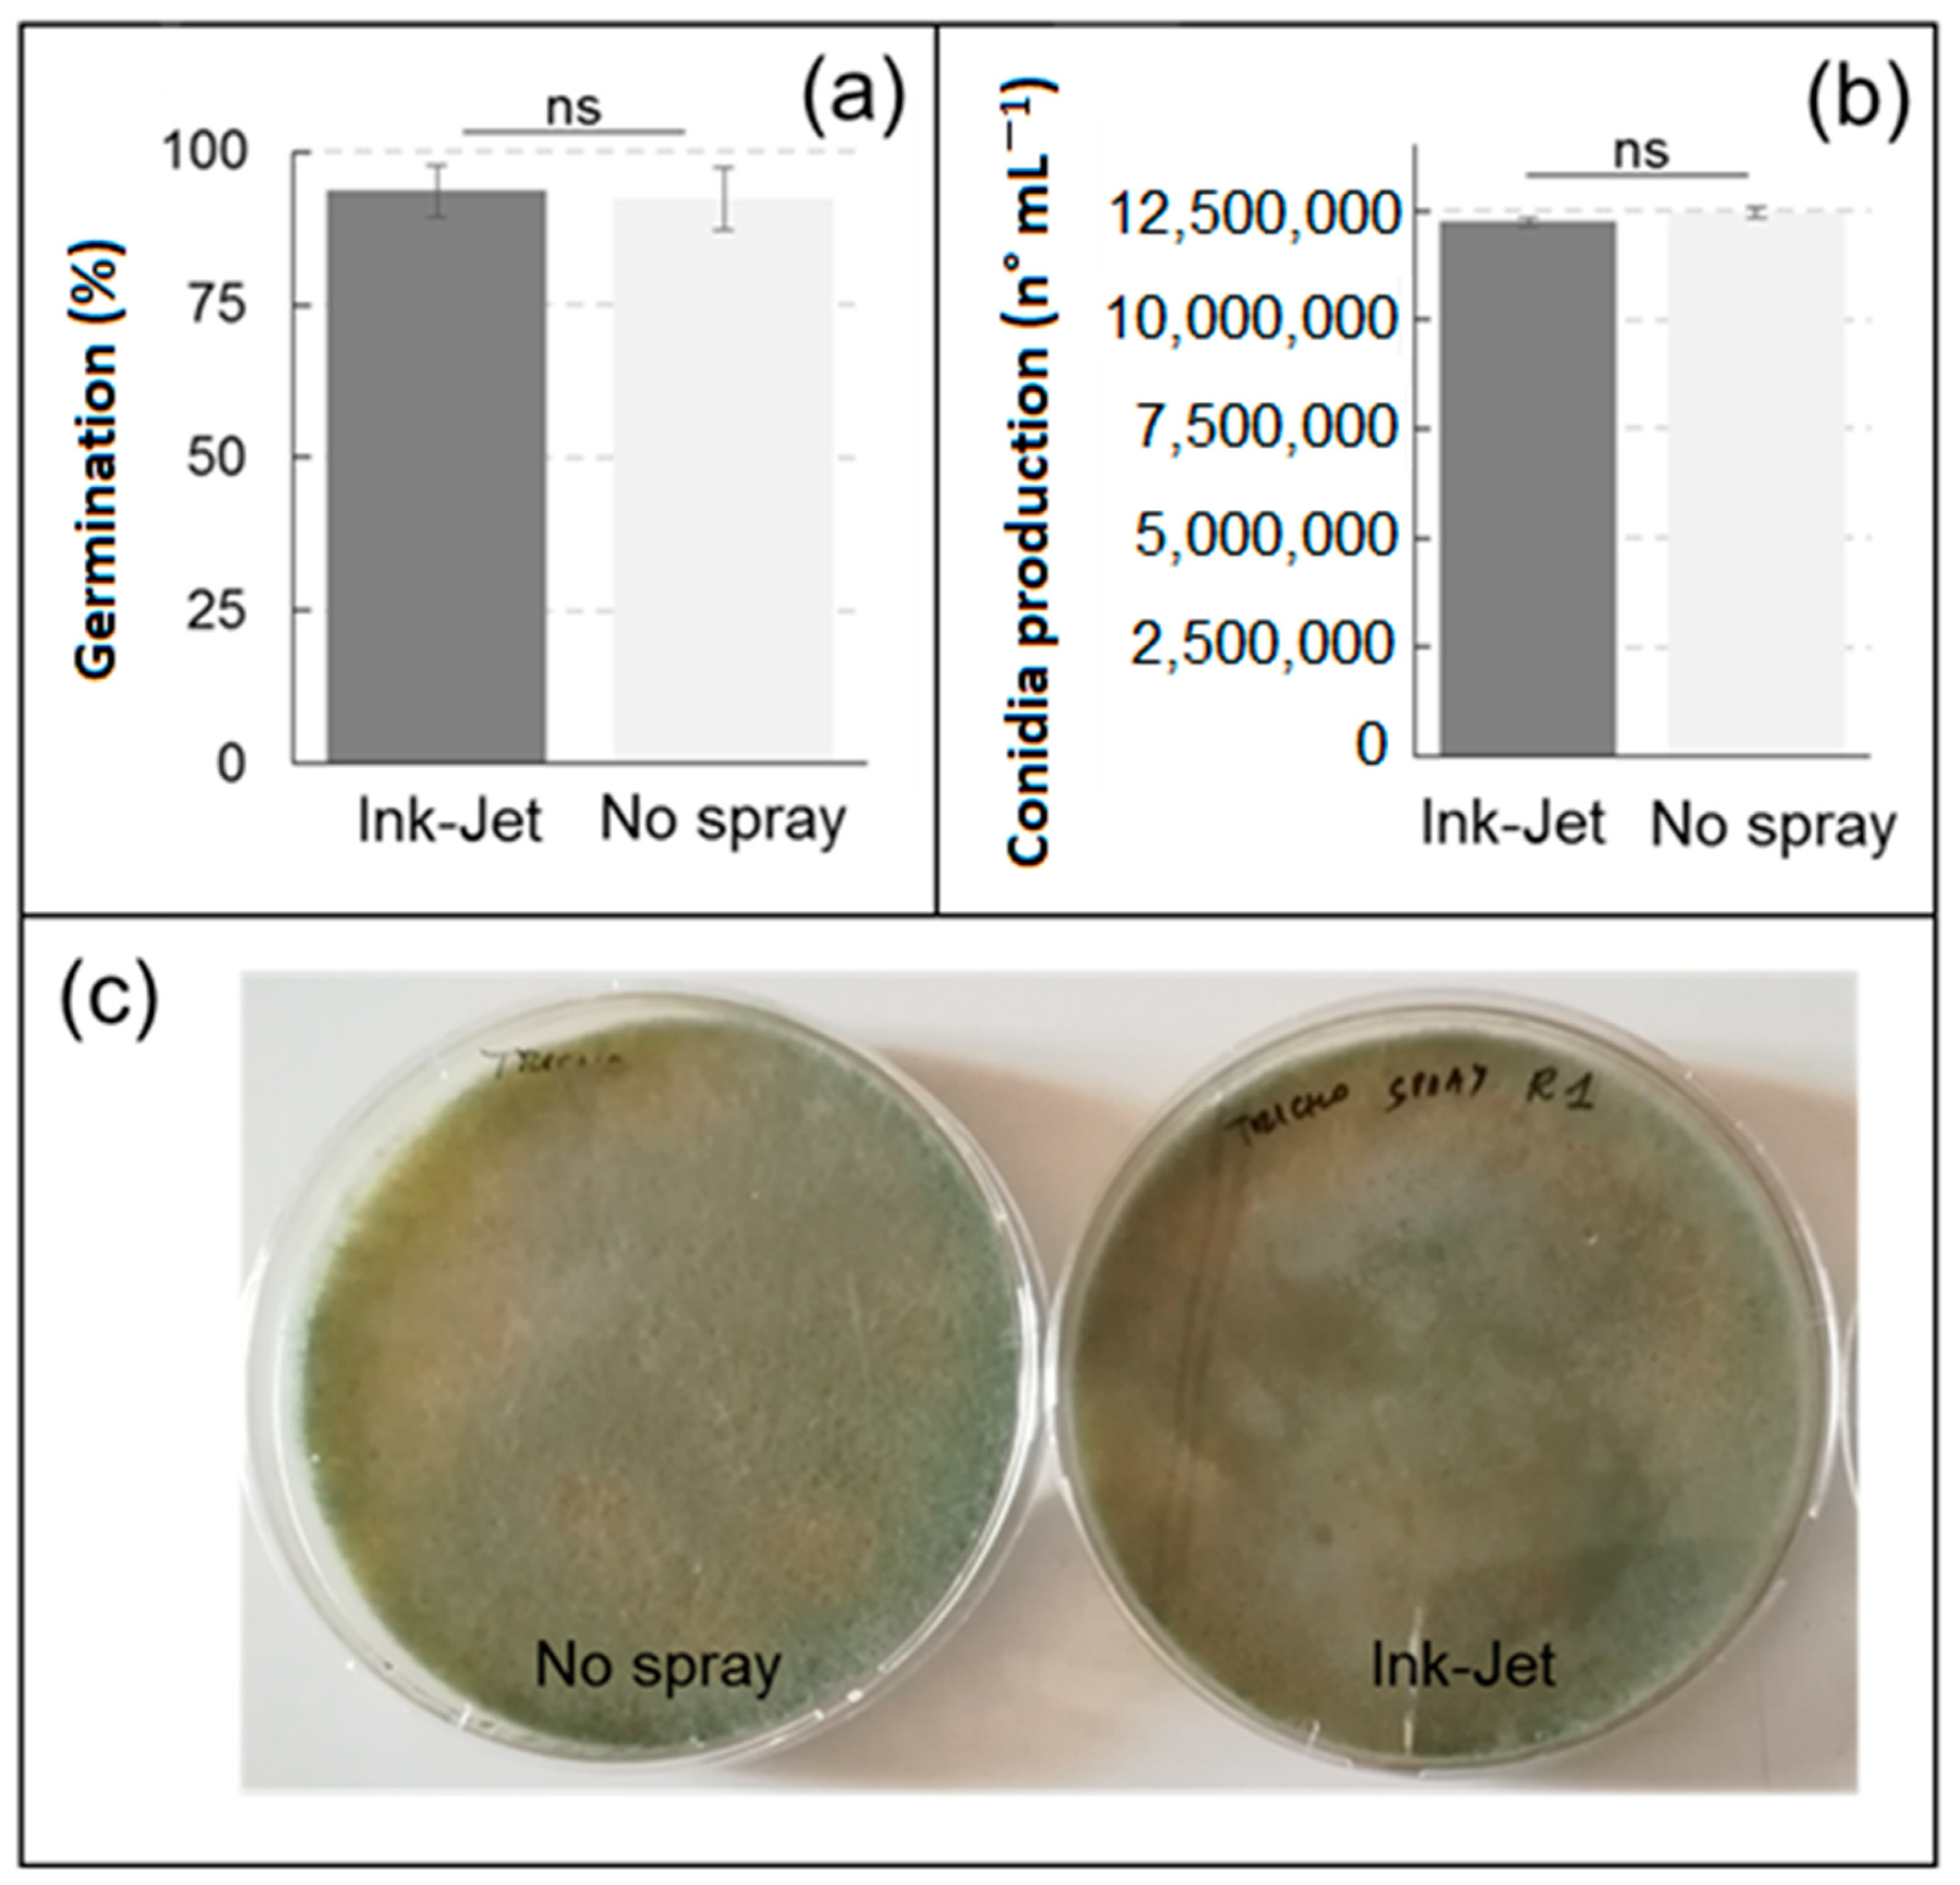
Sensors 23 03053 g003 Sensors 23 03053 g003

Structure, Functionality, Compatibility with Pesticides and Beneficial Microbes, and Potential Applications of a New Delivery System Based on Ink-Jet Technology
Abstract
1. Introduction
- i.
- Testing the compatibility of the new system with herbicides, fungicides, insecticides, and beneficial microbes as well.
- ii.
- Assessing the potentiality of the new system for reduction of chemicals by optimization of droplet size.
- iii.
- Provide a test for potential application to a microgreens production system.
2. Materials and Methods
2.1. Description of the New Sprayer System
2.2. Compatibility Test of Thermal Ink-Jet with Alive Beneficial Microbes
2.2.1. Trichoderma harzianum
2.2.2. Coniothyrium minitans
2.2.3. Glomus mosseae
2.2.4. Bacillus subtilis
2.2.5. Pseudomonas fluorescens
2.3. Compatibility Test of TIJ with Herbicides
2.4. Test for Reducing Application Rate of Insecticides
2.5. Test for Reducing Application Rate of Beneficial Microbes by Modulating Droplet Size
2.6. Application of TIJ System to Microgreens
2.6.1. Drop Distribution Test with Hydrosensitive Papers
2.6.2. Test with Beneficial Microbes
3. Results and Discussion
3.1. Compatibility of TIJ with Benefical Bacteria and Fungi
3.2. Compatibility Test of TIJ with Herbicides
3.3. Test for Reducing Application Rate of Insecticides
3.4. Test for Reducing Application Rate of Beneficial Microbes by Modulating Droplet Size
3.5. Application of TIJ System to Microgreens
4. Conclusions
Supplementary Materials
Author Contributions
Funding
Institutional Review Board Statement
Informed Consent Statement
Data Availability Statement
Conflicts of Interest
References
- Sharma, A.; Kumar, V.; Shahzad, B.; Tanveer, M.; Sidhu, G.P.S.; Handa, N.; Kohli, S.K.; Yadav, P.; Bali, A.S.; Parihar, R.D.; et al. Worldwide pesticide usage and its impacts on ecosystem. SN Appl. Sci. 2019, 1, 1446. [Google Scholar] [CrossRef]
- Barrios-Ulloa, A.; Ariza-Colpas, P.P.; Sánchez-Moreno, H.; Quintero-Linero, A.P.; De la Hoz-Franco, E. Modeling radio wave propagation for wireless sensor networks in vegetated environments: A systematic literature review. Sensors 2022, 22, 5285. [Google Scholar] [CrossRef] [PubMed]
- Carlos, A.D.; Estrada, L.R.; Augusto, C.R.; Patricia, A.C.; Alberto, P.M.; Enrique, R.G.; César, M.O.; Alfredo, O.G.; Andrés, C.M. Monitoring system of environmental variables for a strawberry crop using IoT tools. Proceeds Comput. Sci. 2020, 170, 1083–1089. [Google Scholar] [CrossRef]
- Vasilchenko, A.V.; Poshvina, D.V.; Semenov, M.V.; Timofeev, V.N.; Iashnikov, A.V.; Stepanov, A.A.; Pervushina, A.N.; Vasilchenko, A.S. Triazoles and Strobilurin Mixture Affects Soil Microbial Community and Incidences of Wheat Diseases. Plants 2023, 12, 660. [Google Scholar] [CrossRef]
- Fan, X.; Zhao, M.; Wen, H.; Zhang, Y.; Zhang, Y.; Zhang, J.; Liu, X. Enhancement degradation efficiency of pyrethroid-degrading esterase (Est816) through rational design and its application in bioremediation. Chemosphere 2023, 319, 138021. [Google Scholar] [CrossRef]
- Walker, J.T.; Gardisser, D.R.; Huitink, G.W. Field testing of several pesticide spray atomizers. Appl. Eng. Agric. 1989, 5, 319–323. [Google Scholar] [CrossRef]
- Ucar, T.; Hall, F.R. Windbreaks as a pesticide drift mitigation strategy: A review. Pest Manag. Sci. Former. Pestic. Sci. 2001, 57, 663–675. [Google Scholar] [CrossRef] [PubMed]
- Nansen, C.; Ferguson, J.C.; Moore, J.; Groves, L.; Emery, R.; Garel, N.; Hewitt, A. Optimizing pesticide spray coverage using a novel web and smartphone tool, SnapCard. Agron. Sustain. Dev. 2015, 35, 1075–1085. [Google Scholar] [CrossRef]
- Ebert, T.A.; Downer, R.A. A different look at experiments on pesticide distribution. Crop Prot. 2006, 25, 299–309. [Google Scholar] [CrossRef]
- Jensen, P.K.; Olesen, M.H. Spray mass balance in pesticide application: A review. Crop Prot. 2014, 61, 23–31. [Google Scholar] [CrossRef]
- Warneke, B.W.; Zhu, H.; Pscheidt, J.W.; Nackley, L.L. Canopy spray application technology in specialty crops: A slowly evolving landscape. Pest Manag. Sci. 2021, 77, 2157–2164. [Google Scholar] [CrossRef]
- Fleming, L. Finding the organizational sources of technological breakthroughs: The story of Hewlett-Packard’s thermal ink-jet. Ind. Corp. Change 2002, 11, 1059–1084. [Google Scholar] [CrossRef]
- Li, J.; Rossignol, F.; Macdonald, J. Inkjet printing for biosensor fabrication: Combining chemistry and technology for advanced manufacturing. Lab A Chip 2015, 15, 2538–2558. [Google Scholar] [CrossRef] [PubMed]
- Zub, K.; Hoeppener, S.; Schubert, U.S. Inkjet Printing and 3D Printing Strategies for Biosensing, Analytical, and Diagnostic Applications. Adv. Mater. 2022, 34, 2105015. [Google Scholar] [CrossRef] [PubMed]
- Kyriacou, M.C.; Rouphael, Y.; Di Gioia, F.; Kyratzis, A.; Serio, F.; Renna, M.; Santamaria, P. Micro-scale vegetable production and the rise of microgreens. Trends Food Sci. Technol. 2016, 57, 103–115. [Google Scholar] [CrossRef]
- Mir, S.A.; Shah, M.A.; Mir, M.M. Microgreens: Production, shelf life, and bioactive components. Crit. Rev. Food Sci. Nutr. 2017, 57, 2730–2736. [Google Scholar] [CrossRef]
- Tavan, M.; Wee, B.; Brodie, G.; Fuentes, S.; Pang, A.; Gupta, D. Optimizing sensor-based irrigation management in a soilless vertical farm for growing microgreens. Front. Sustain. Food Syst. 2021, 4, 622720. [Google Scholar] [CrossRef]
- Barile, E.; Bonanomi, G.; Antignani, V.; Zolfaghari, B.; Sajjadi, S.E.; Scala, F.; Lanzotti, V. Saponins from Allium minutiflorum with antifungal activity. Phytochemistry 2007, 68, 596–603. [Google Scholar] [CrossRef]
- Clapp, J. Explaining growing glyphosate use: The political economy of herbicide-dependent agriculture. Glob. Environ. Change 2021, 67, 102239. [Google Scholar] [CrossRef]
- van den Berg, H.; Zaim, M.; Yadav, R.S.; Soares, A.; Ameneshewa, B.; Mnzava, A.; Ejov, M. Global trends in the use of insecticides to control vector-borne diseases. Environ. Health Perspect. 2012, 120, 577–582. [Google Scholar] [CrossRef]
- Simon-Delso, N.; Amaral-Rogers, V.; Belzunces, L.P.; Bonmatin, J.M.; Chagnon, M.; Downs, C.; Wiemers, M. Systemic insecticides (neonicotinoids and fipronil): Trends, uses, mode of action and metabolites. Environ. Sci. Pollut. Res. 2015, 22, 5–34. [Google Scholar] [CrossRef] [PubMed]
- Chouyia, F.Z.; Fiorentino, N.; Rouphael, Y.; Ventorino, V.; Fechtali, T.; Visconti, D.; Cozzolino, E.; Idbella, M.; Giordano, M.; Fagnano, M. Assessing the effect of P-solubilizing bacteria and mycorrhizal fungi on tomato yield and quality under different crop rotations. Sci. Hortic. 2022, 293, 110740. [Google Scholar] [CrossRef]
- Bonanomi, G.; Zotti, M.; Idbella, M.; Cesarano, G.; Al-Rowaily, S.L.; Abd-ElGawad, A.M. Mixtures of organic amendments and biochar promote beneficial soil microbiota and affect Fusarium oxysporum f. sp. lactucae, Rhizoctonia solani and Sclerotinia minor disease suppression. Plant Pathol. 2021, 71, 818–829. [Google Scholar]
- Bellini, A.; Gilardi, G.; Idbella, M.; Zotti, M.; Pugliese, M.; Bonanomi, G.; Gullino, M.L. Trichoderma enriched compost, BCAs and potassium phosphite control Fusarium wilt of lettuce without affecting soil microbiome at genus level. Appl. Soil Ecol. 2023, 182, 104678. [Google Scholar] [CrossRef]
- Thakore, Y. The biopesticide market for global agricultural use. Ind. Biotechnol. 2006, 2, 194–208. [Google Scholar] [CrossRef]
- Parnell, J.J.; Berka, R.; Young, H.A.; Sturino, J.M.; Kang, Y.; Barnhart, D.M.; DiLeo, M.V. From the lab to the farm: An industrial perspective of plant beneficial microorganisms. Front. Plant Sci. 2016, 7, 1110. [Google Scholar] [CrossRef]
- Woo, S.L.; Ruocco, M.; Vinale, F.; Nigro, M.; Marra, R.; Lombardi, N.; Lorito, M. Trichoderma-based products and their widespread use in agriculture. Open Mycol. J. 2014, 8, 71–126. [Google Scholar] [CrossRef]
- Wang, X.Q.; Zhao, D.L.; Shen, L.L.; Jing, C.L.; Zhang, C.S. Application and mechanisms of Bacillus subtilis in biological control of plant disease. In Role of Rhizospheric Microbes in Soil; Springer: Singapore, 2018; pp. 225–250. [Google Scholar]
- Matthews, G.; Bateman, R.; Miller, P. Pesticide Application Methods; John Wiley & Sons: Hoboken, NJ, USA, 2014. [Google Scholar]
- Whipps, J.M. Developments in the biological control of soil-borne plant pathogens. In Advances in Botanical Research; Academic Press: Cambridge, MA, USA, 1997; Volume 26, pp. 1–134. [Google Scholar]
- Chen, S.; Lan, Y.; Zhou, Z.; Ouyang, F.; Wang, G.; Huang, X.; Deng, X.; Cheng, S. Effect of droplet size parameters on droplet deposition and drift of aerial spraying by using plant protection UAV. Agronomy 2020, 10, 195. [Google Scholar] [CrossRef]

| Active Compound and Commercial Name | Species | Concentration | Spray | ST20 | ST50 |
|---|---|---|---|---|---|
| Abamectin (VERTIMEC) | G. mellonella | 1 μL mL−1 | 100 ± 0 a | 100 ± 0 a | 100 ± 0 a |
| 0.3 μL mL−1 | 83 ± 6 b | 91 ± 6 a | 90 ± 9 a | ||
| 0.1 μL mL−1 | 5 ± 3 a | 9 ± 5 a | 7 ± 5 a | ||
| 0.03 μL mL−1 | 0 ± 0 a | 0 ± 0 a | 0 ± 0 a | ||
| 0.01 μL mL−1 | 0 ± 0 a | 0 ± 0 a | 0 ± 0 a | ||
| S. carnaria | 1 μL mL−1 | 100 ± 0 a | 100 ± 0 a | 100 ± 0 a | |
| 0.3 μL mL−1 | 78 ± 8 a | 81 ± 9 a | 79 ± 11 a | ||
| 0.1 μL mL−1 | 0 ± 0 a | 0 ± 0 a | 0 ± 0 a | ||
| 0.03 μL mL−1 | 0 ± 0 a | 0 ± 0 a | 0 ± 0 a | ||
| 0.01 μL mL−1 | 0 ± 0 a | 0 ± 0 a | 0 ± 0 a |
| Active Compound and Commercial Name | Species | Concentration | Spray | ST20 | ST50 |
|---|---|---|---|---|---|
| Deltametrine (DECIS) | G. mellonella | 0.6 μL mL−1 | 100 ± 0 a | 100 ± 0 a | 100 ± 0 a |
| 0.1 μL mL−1 | 95 ± 3 a | 91 ± 9 a | 87 ± 8 a | ||
| 0.06 μL mL−1 | 45 ± 3 a | 48 ± 8 a | 51 ± 11 a | ||
| 0.01 μL mL−1 | 0 ± 0 a | 0 ± 0 a | 0 ± 0 a | ||
| 0.006 μL mL−1 | 0 ± 0 a | 0 ± 0 a | 0 ± 0 a | ||
| S. carnaria | 0.6 μL mL−1 | 100 ± 0 a | 100 ± 0 a | 100 ± 0 a | |
| 0.1 μL mL−1 | 85 ± 2 a | 81 ± 9 a | 86 ± 8 a | ||
| 0.06 μL mL−1 | 35 ± 12 a | 43 ± 13 a | 38 ± 9 a | ||
| 0.01 μL mL−1 | 0 ± 0 a | 0 ± 0 a | 0 ± 0 a | ||
| 0.006 μL mL−1 | 0 ± 0 a | 0 ± 0 a | 0 ± 0 a |
Disclaimer/Publisher’s Note: The statements, opinions and data contained in all publications are solely those of the individual author(s) and contributor(s) and not of MDPI and/or the editor(s). MDPI and/or the editor(s) disclaim responsibility for any injury to people or property resulting from any ideas, methods, instructions or products referred to in the content. |
© 2023 by the authors. Licensee MDPI, Basel, Switzerland. This article is an open access article distributed under the terms and conditions of the Creative Commons Attribution (CC BY) license (https://creativecommons.org/licenses/by/4.0/).
Share and Cite
Idbella, M.; Giusti, D.; Gulli, G.; Bonanomi, G. Structure, Functionality, Compatibility with Pesticides and Beneficial Microbes, and Potential Applications of a New Delivery System Based on Ink-Jet Technology. Sensors 2023, 23, 3053. https://doi.org/10.3390/s23063053
Idbella M, Giusti D, Gulli G, Bonanomi G. Structure, Functionality, Compatibility with Pesticides and Beneficial Microbes, and Potential Applications of a New Delivery System Based on Ink-Jet Technology. Sensors. 2023; 23(6):3053. https://doi.org/10.3390/s23063053
Chicago/Turabian StyleIdbella, Mohamed, Domenico Giusti, Gianluca Gulli, and Giuliano Bonanomi. 2023. "Structure, Functionality, Compatibility with Pesticides and Beneficial Microbes, and Potential Applications of a New Delivery System Based on Ink-Jet Technology" Sensors 23, no. 6: 3053. https://doi.org/10.3390/s23063053
APA StyleIdbella, M., Giusti, D., Gulli, G., & Bonanomi, G. (2023). Structure, Functionality, Compatibility with Pesticides and Beneficial Microbes, and Potential Applications of a New Delivery System Based on Ink-Jet Technology. Sensors, 23(6), 3053. https://doi.org/10.3390/s23063053

